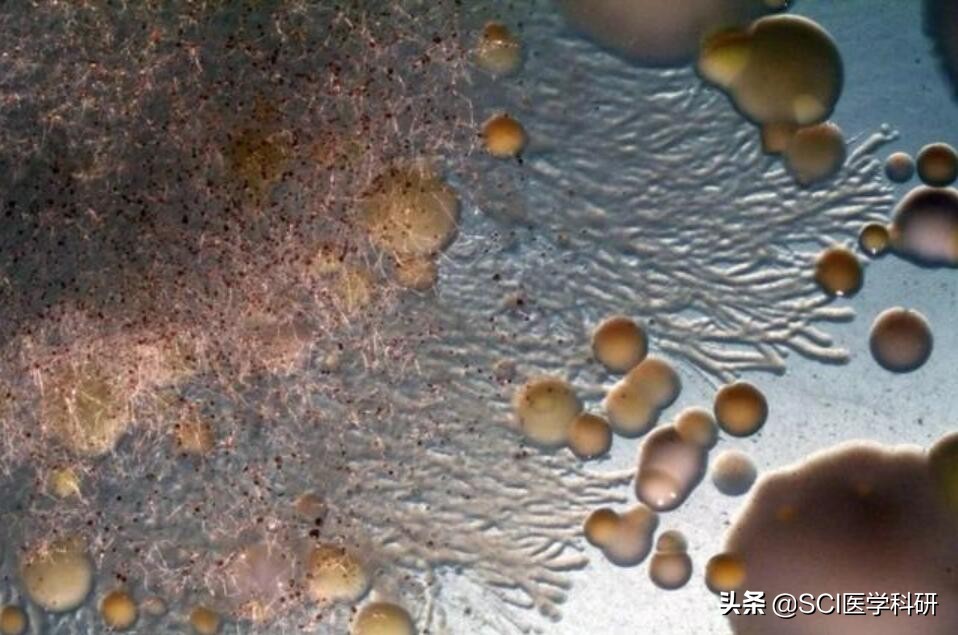
人为什么会长头皮屑简单的回答,头皮屑是什么细胞产生的

在我们的头顶上,有一种酵母菌在不停地大吃大喝,头皮简直是它们的天堂;马拉色菌在头皮上的大量繁殖引起头皮角质层的过度增生,从而促使角质层细胞异常脱落即为头屑。为什么有的人头屑很多,该如何预防呢?

头皮屑是头皮细胞新陈代谢的产物,在细胞成熟之后会形成微小的肉眼看不见的微粒脱落。当头皮功能失调时,会导致一些异常微粒出现,也就是我们平常能看到的头皮屑。
拉色菌是人体正常皮肤上最常见的定植菌群,作为一种条件致病菌,在易感因素作用下,可引起多种浅部、深部真菌病。

已知微生物可以调节固有免疫及获得性免疫,而马拉色菌作为最丰富的皮肤真核生物,占皮肤真菌菌群总数的50%~80%。马拉色菌主要定植在成人的躯干、头部以及手臂上,与多种皮肤疾病有关,如脂溢性皮炎、特应性皮炎、银屑病等。马拉色菌在不同的环境下可以诱导或抑制炎症反应,种类及其功能的数量和多样性以其与皮肤其他微生物群的潜在相互作用,也使这种关系变得复杂。

在洗发水市场中,去屑洗发水占比高达35%。虽然去屑产品一代接一代更新,但是70%的人群认为去屑效果并不满意,原因可能是目前对于头皮屑的处理方法主要集中于马拉色菌上,但是头皮屑影响因素非常多,涉及头皮微生态、角质层脂质、头皮屏障等多重因素,并不仅仅马拉色菌单独作用的结果。另一方面,抗真菌治疗后,又很快复发,说明反复使用去屑剂会产生耐药性,因此针对单纯抗真菌治疗头皮屑可能不是唯一有效的对策,需要采取综合治疗来恢复头皮微生物之间的稳态。

另一方面,头皮屑的治疗除了直接涂抹相关抗真菌成分外,还有通过口服益生菌剂来降低头皮的刺激和瘙痒感。口服益生菌剂虽然不直接和头发微生物发生作用,但却可以影响微生物菌群的平衡,从而降低头皮屑的发生。因此通过口服益生菌剂的使用来引起头皮微生物组成和菌群结构的变化有待进一步的深入研究, 从而获得更有针对地抑制头皮有害微生物生长,同时促进有益微生物生长,最终达到减少头皮屑发生的关键微生物类群。

头皮屑是由真菌(马拉色菌)感染引起的,因此在日常生活中,一方面要提高头皮护理意识,另一方面要调整生活规律、避免吃煎炸、油腻、辛辣等食品,可起到调节、保护头皮自身平衡、抑制马拉色菌过度繁殖,从而减少头皮屑发生的几率。我们注意以下情况能得到很好的改善:

1. 洗发精没洗净。
2. 使用脱脂力过强的不良洗发精。
3. 头皮上的皮脂过多。
4. 饮食不当、饮酒、及刺激性食物。
5. 自律神经容易紧张。
6. 睡眠不足、疲劳。
7. 胃肠障碍,营养不均衡,缺乏维生素A、B6、B2。
8. 使用不良的美发用品。
9. 内分泌不正常的因素。
图片来自网络,侵权请联系删除
特别声明:本文系 SCI医学科研论文助手编译 整理,如有关于作品内容、版权或其它问题请告知,我们将尽快删除相关内容。